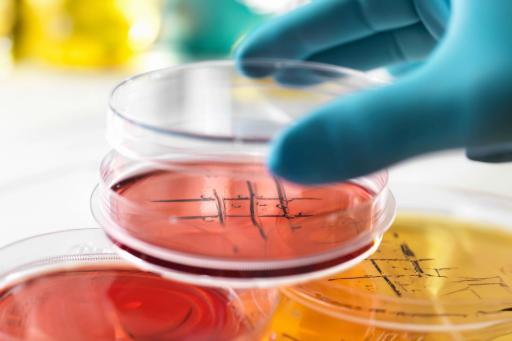

Prep and Store Your Plasma Samples, Hematology, Urine, Tissue, and Other Clinical Samples
Your clinical lab might have a smaller budget than industry labs, but you need the same reliable equipment to prepare and store your samples.
And you deserve the same level of excellent customer service to make sure your workday runs smoothly.
Find the curated collection of necessities for your sample type below and save yourself some mental energy.

Blood and Plasma
-
Hematology CBC to measure red blood cells, white blood cells, hemoglobin, hematocrit, and platelets
-
Blood chemistry panels include tests like basic metabolic panel (BMP) and comprehensive metabolic panel (CMP)
-
ELIZA assay to detect specific proteins, hormones, or antibodies
-
Flow cytometry
-
CDC lipid panels

DNA & RNA
- PCR and real-time PCR for DNA or RNA detection and quantification
-
Next-Generation Sequencing (NGS)
-
Microarrays for genotyping and measuring gene expression levels
- Southern and Northern Blotting

Urine
- Urinalysis including dipstick, macroscopic and microscopic examinations
- Urine biochemical analysis
- Microbiological testing on urine cultures
-
Immunoassay for hCG
-
Immunoassay and GC-MS for drug testing
-
Specialized tests such as 24-hour urine collection, urine protein electrophoresis, and urine osmolality test
-
Cytological examination for indication of urinary tract cancers.
Cytological examination for indication of urinary tract cancers.

Enzymes & Proteins
- ELISA assays
- Western blotting for protein detection and analysis
-
Mass Spectrometry (MS) and LC-MS
- Immunoassays: radioimmunoassay, chemiluminescent immunoassay, etc for detecting specific proteins or enzymes
Cell Cultures
- Microscopy
-
Flow cytometry for cell counting, sorting, and biomarker detection
-
Cell viability assays such as trypan blue exclusion or MTT assay for assessing cell health and proliferation
- Analyzed for heavy metals, pathogens, and other pollutants.
-
Cytogenetic analysis including karyotyping for studying chromosomal abnormalities

Tissues
- Histopathology
-
Immunohistochemistry (IHC) for detecting specific antigens in tissue sections.
-
In situ hybridization (ISH) for localizing specific DNA or RNA sequences in tissues.
-
High-throughput microarrays
- Cytology tests such as Pap smears
Tell us what sample you’re working with, we’ll help you prep and store it.
Work with a variety of clinical samples? Here are your prep necessities.
Save budget, time, and stress with these prep basics for your clinical samples in one simple order. We’ve curated this collection so you don’t have to manage multiple suppliers.
You have enough mental load to carry. Let us help you find what you need.
Storage for your reagents, hematology, urinalysis, NGS, and other clinical samples is a critical part of your lab
Need a reliable ultra-low freezer with alarm systems? Glass-door fridge for your reagents and samples that are waiting to be tested?
Whatever your process, these storage necessities help keep you organized.
Want help building a PDF for budget approval? Complete this form
Fill in the form and we’ll take the work off your shoulders. You’ll get a printable PDF with everything you need for budget approval.
Want help building a PDF for budget approval? Complete this form
Fill in the form and we’ll take the work off your shoulders. You’ll get a printable PDF with everything you need for budget approval.









